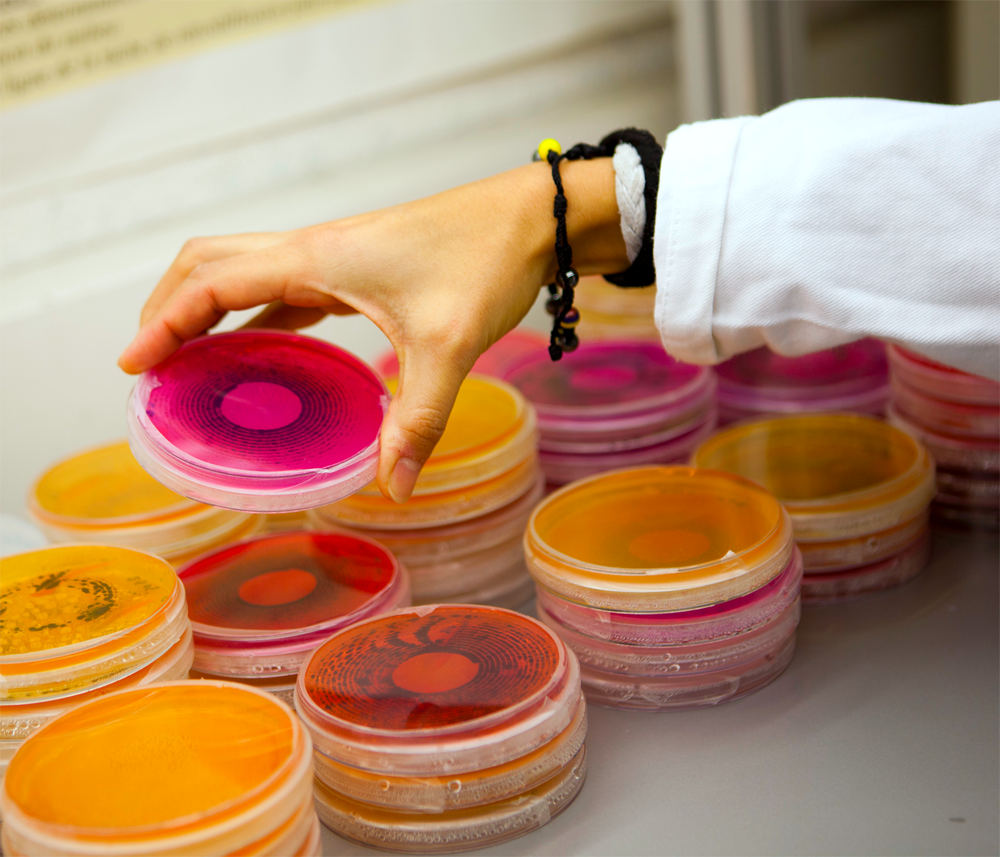

Après le grand enthousiasme du début des années 2010, il a fallu se résigner. Les micro-algues comme solution miracle aux biocarburants de 3eme génération, ce n'était pas demain. Pour autant, les recherches avancent désormais à grand pas pour lever les derniers verrous technologiques ou économiques.
Au début des années 2010 beaucoup y ont cru. Les micro-algues seraient LA solution pour les biocarburants de 3eme génération. Avec un rendement à l’hectare incomparable par rapport aux plantes terrestres (au moins 5 fois plus que le blé par exemple), il n’y avait pas de doute, ça allait marcher. Oui, mais… c’était sans compter sur la baisse des prix du pétrole et les nombreux défis technologiques qu’il fallait passer pour rendre la filière économiquement viable.
Sélectionner les bonnes souches
On estime qu’il existe entre 200 000 et un million de souches de micro-algues, mais seules 30 000 sont décrites et une dizaine couramment utilisées pour la recherche. A l’instar des cultures terrestres, la sélection est essentielle pour atteindre une productivité maximale et devenir rentable. C’est donc l’un des axes majeurs de la recherche aujourd’hui. Que ce soit en France, sur la plateforme HélioBiotec par exemple ou d’autres centres scientifiques mondiaux, on cherche quelles sont les souches qui se reproduisent le plus vite, synthétisent le plus de biomasse ou comment les booster pour qu’elles le fassent.
Valoriser les sous-produits d’autres industries
Pour renforcer sa rentabilité, les pilotes et démonstrateurs semi-industriels de la filière micro-algues parient sur l’intégration dans des chaînes d’économie circulaire : utiliser les sous-produits, les déchets ou les rejets d’autres industries pour alimenter les micro-algues ou leur environnement de culture. En France, par exemple, le projet Trans’alg, à Libourne porté par la société Fermentalg, doit utiliser les sous-produits de la vinification ou d’autres cultures riches en carbone pour nourrir les algues. Quant au démonstrateur Cimentalgue, porté par Ciments Calcia et Algosource Technologie, à St-Nazaire, il doit utiliser les effluents gazeux d’une cimenterie.
Que d’eau, que d’eau !
L’un des défis technico-économiques le plus important de l’exploitation des micro-algues est celui de l’eau. Car pour extraire efficacement leur production il faut s’en débarrasser. Et cela revient cher. Plusieurs voies de recherche sont actuellement testées : des techniques d’extraction par voie humide (projet BioFat), la liquéfaction hydrothermale (CEA) ou la culture à l’air libre avec très peu d’eau dans des photobioréacteurs. Les premiers résultats probants commencent à voir le jour.
Développer l’aval de la filière
Même si il faudra encore quelques années pour les algocarburants soient utilisés de manière massive, il y a tout lieu de penser qu’une filière industrielle verra vraiment le jour, dès lors que la production présente un avantage environnemental. D’autant que la culture des micro-algues tend à se développer grâce à l’impulsion donnée par d’autres marchés à plus grande valeur ajoutée : cosmétiques, chimie verte, nutrition comme l’illustre la plateforme Algosolis qui met en relation industriels et chercheurs autour de la culture et l’exploitation des micro-algues.
Par Sophie Hoguin

Il y avait bfs mais les pétroliers et producteurs ont déja eu leur peau
http://maximechaix.info/?p=2085
Intéressant, si c’était une solution pour valoriser le stock d’algues vertes des cotes atlantiques.
Réagissez à cet article
Connectez-vous
Vous avez déjà un compte ? Connectez-vous et retrouvez plus tard tous vos commentaires dans votre espace personnel.
Vous n'avez pas encore de compte ?
Inscrivez-vous !